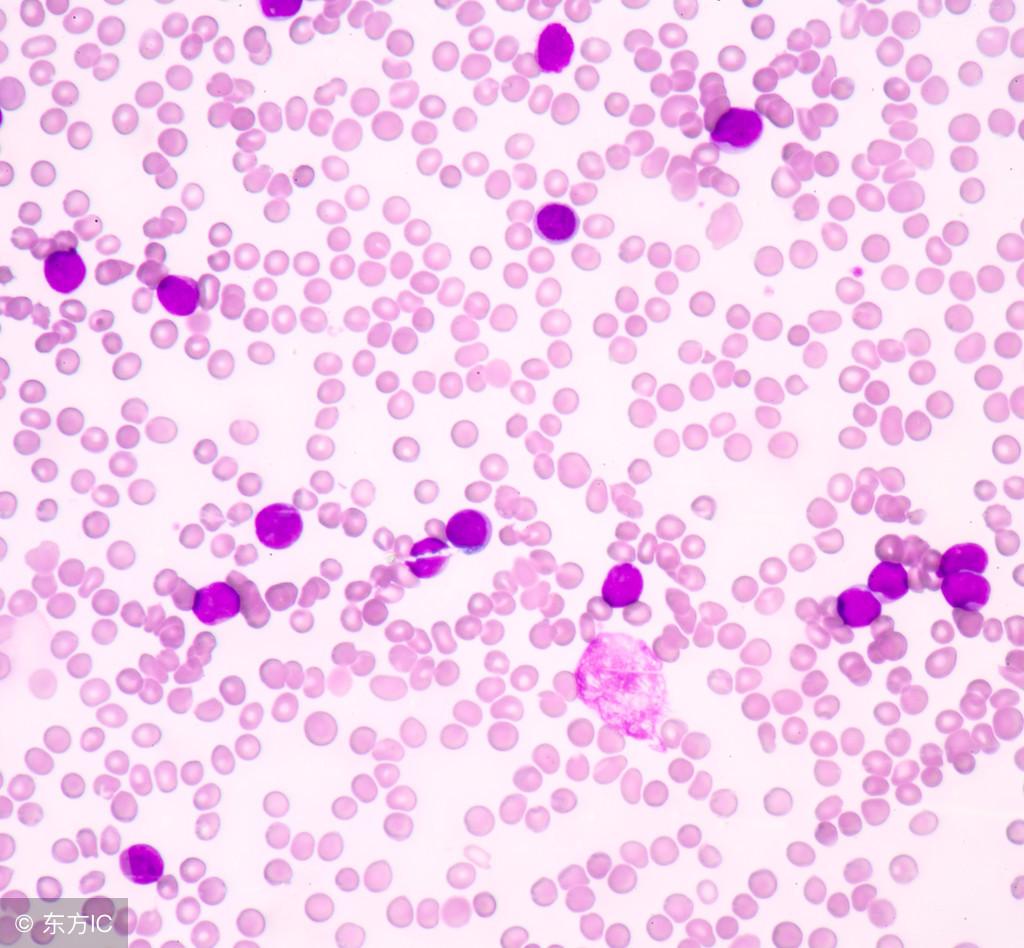
腋窝下的瘤是不是淋巴瘤,腋窝下有硬块就一定是淋巴结吗

腋窝下有肉疙瘩有点疼怎么回事,腋下有肉疙瘩一般常见的问题有两种,一种可能是副乳,一种可能是腋下的淋巴结肿大,多因为存在机体的免疫功能下降或者是机体存在感染引起,比如最近有感冒的情况发生等。

你可以注意一下,硬块的大小;软硬度;是否活动;边缘是否整齐;有没有与周围组织粘连;有无触痛感等。如果一直没有长大也没有增加数量的话,应该是局部的一个小瘤子(脂肪瘤等,良性的可能大)。如果增大,增多,加硬的话要赶快去医院。这是因为腋下的淋巴结肿大往往和胃、乳腺的肿瘤有关。
虽然一般是考虑有淋巴结肿大的可能,但同时还是有乳房病变导致的可能,医生是建议检查乳腺彩超。如果腋下的疙瘩是病菌感染引起的淋巴结肿大造成的,建议您可以先使用一些抗菌消炎的药物治疗,多喝水,注意休息。
淋巴结炎多数有明显的感染灶,且常为局限性淋巴结肿大,有疼痛及压痛,一般直径不超过2~3cm,抗炎治疗后会缩小。一定要予以重视,作进一步检查确定,一般是可以口服头孢类的药物来治疗的。
同时也不排除是皮脂腺囊肿,是最为多见的一种皮肤良性肿瘤,可以手术切除的,可以选择微创手术,术后应注意消炎避免感染。

一个小小的有痛感的肉疙瘩,是可以由以上多种病变所导致的。不论是淋巴结肿大还是乳腺部位的相关疾病等,都应及时去医院进行必要的检查,绝对不能忽视问题的存在,尽早确诊,尽早选择合适的治疗方案,要对自己的身体负起责任。
小小的一个肉疙瘩也有可能是副乳,副乳也会有点疼的,我们一定要注意的,那么如果是副乳的话应该怎么消除呢,方法有很多种看我们如何选择的。